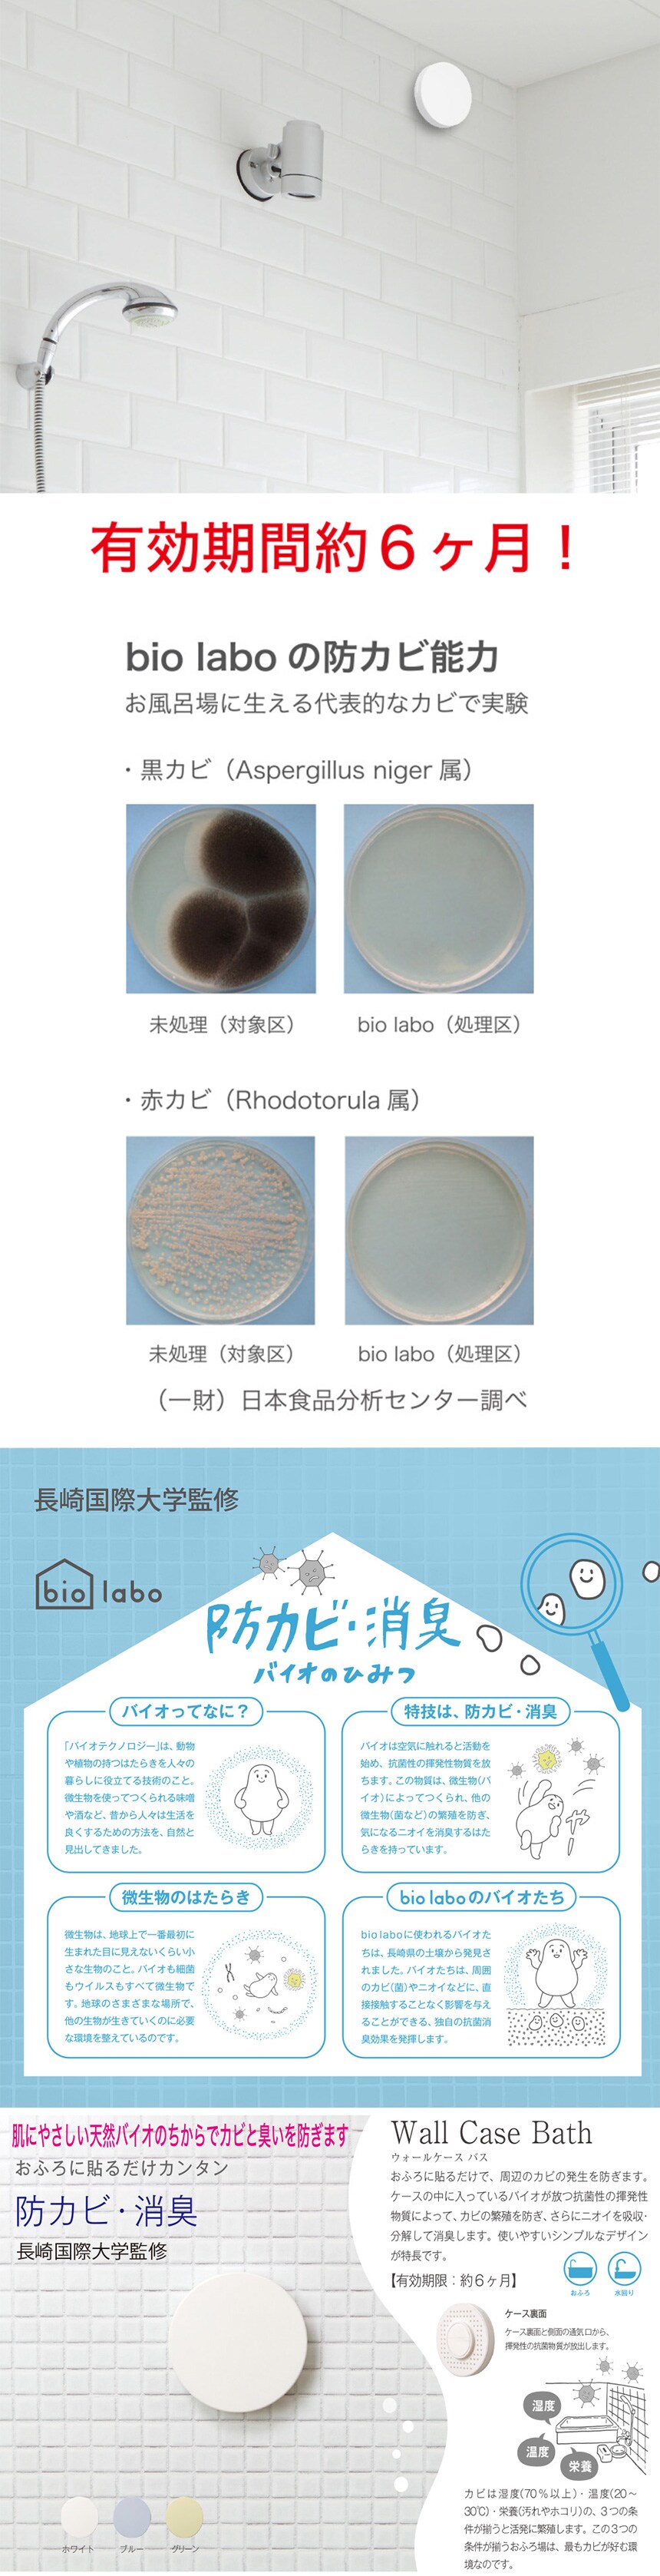

お試し費用
税込・送料込
参考価格
オープン
3790
円
1個あたり
947.5
円
※たまるdポイントは、dポイント(通常)34ポイントです。
dカードでお支払ならポイント5倍
※ポイントは通常ポイントが5倍になります
お試し費用 税込・送料込
3790
円
数量
残り
商品仕様
- 商品名
- Wall Case Bath ウォールケースバス (ホワイト)×4個
- セット内容
- 4個
- 申込可能個数
- 5個
- 発送予定日
- 通常5日前後(発送日カレンダー休日除く)
- 配送形態
-
通常配送
詳細は こちら
- 管理番号
- 6987825-0004
商品詳細
お風呂に貼るだけで、周辺のカビの発生を防ぎます。
ケースの中に入っているバイオ(微生物)が放つ抗菌性の揮発性物質によってカビの繁殖を防ぎます。さらに消臭効果もあります。
バスシリーズに使われるバイオは遺伝子解析などの性状分析を行っており、検査の結果、安全性(溶血毒素:陰性[安全] バイオセーフティーレベル1)を確認しています。
また、抗菌や消臭方法は科学物質を利用するものでないため、安全性が非常に高いというメリットがあります。
高温多湿の環境下でも抗菌能力や消臭能力を発揮するのがバスシリーズで使われるバイオの特徴。
悪臭の原因物質でもあるアンモニアなどに効果を持ちます。

注意事項
お申込みの際は 「商品情報」に記載されている「注意事項」を必ずご確認ください。
【キャンセルについて】
※お申込み後のキャンセルはお受けできません。
記載されている内容を必ずご確認いただき、お届けする商品セットにご納得いただきましたうえでお申し込みください。
※パッケージ変更や商品リニューアル(成分など含む)等により、参考の掲載画像とお届け商品が多少異なる場合がございます。
また、[新たな加工食品の原料原産地表示制度]の経過措置期間の終了により、商品詳細内に記載の原産国・原材料の表記が旧表記の場合がございます。
あらかじめご了承いただいた上でお申込みください。なお、本理由によるお申込み後のキャンセル・返品交換は対応いたしかねます。
【お支払いについて】
※お支払い方法は、電話料金合算払い、クレジットカード、dポイントの利用となります。
【発送・お届け・商品について】
※お申込み頂きました商品の同梱、お届けの日時指定はいたしかねます。
※会員様のご都合でお受取りいただけない場合、商品の再発送や返金はいたしかねます。
また、お届け日時のご指定は、お受けできません。宅配業者からの不在票にてご対応ください。
※発送予定日は前後する場合がございます。また商品によって発送日が異なります。
※dショッピングサンプル百貨店よりお届けする商品は、ご利用いただいた後のご感想をいただくことを目的としており、転売等は固く禁じます。
転売等、目的以外での利用が確認された場合は、サービス利用を停止させていただきます。
【キャンセルについて】
※お申込み後のキャンセルはお受けできません。
記載されている内容を必ずご確認いただき、お届けする商品セットにご納得いただきましたうえでお申し込みください。
※パッケージ変更や商品リニューアル(成分など含む)等により、参考の掲載画像とお届け商品が多少異なる場合がございます。
また、[新たな加工食品の原料原産地表示制度]の経過措置期間の終了により、商品詳細内に記載の原産国・原材料の表記が旧表記の場合がございます。
あらかじめご了承いただいた上でお申込みください。なお、本理由によるお申込み後のキャンセル・返品交換は対応いたしかねます。
【お支払いについて】
※お支払い方法は、電話料金合算払い、クレジットカード、dポイントの利用となります。
【発送・お届け・商品について】
※お申込み頂きました商品の同梱、お届けの日時指定はいたしかねます。
※会員様のご都合でお受取りいただけない場合、商品の再発送や返金はいたしかねます。
また、お届け日時のご指定は、お受けできません。宅配業者からの不在票にてご対応ください。
※発送予定日は前後する場合がございます。また商品によって発送日が異なります。
※dショッピングサンプル百貨店よりお届けする商品は、ご利用いただいた後のご感想をいただくことを目的としており、転売等は固く禁じます。
転売等、目的以外での利用が確認された場合は、サービス利用を停止させていただきます。
発送日カレンダー
休業日
こちらの情報は 2024-05-22 15:54:47.0
での情報となります。
もっと見る
この商品の口コミ
口コミはまだ投稿されていません。
※dショッピングのページに遷移いたします。
サンプル百貨店のその他商品
-
 洗たく槽クリーナー カビトルネード Neo ドラム式用 リベ...3490円(698円/個)
洗たく槽クリーナー カビトルネード Neo ドラム式用 リベ...3490円(698円/個) -
 [冷凍]ロッテ モナ王 バニラ 160ml×22個 | 小さ...3990円(181.4円/個)
[冷凍]ロッテ モナ王 バニラ 160ml×22個 | 小さ...3990円(181.4円/個) -
 たらみ おいしい蒟蒻ゼリー りんご味 150g×12個 | ...2190円(182.5円/個)
たらみ おいしい蒟蒻ゼリー りんご味 150g×12個 | ...2190円(182.5円/個) -
 キーコーヒー 香味まろやか水出し珈琲 30g×30袋入 | ...4090円
キーコーヒー 香味まろやか水出し珈琲 30g×30袋入 | ...4090円 -
 [冷蔵]日本ルナ スキル バニラ 80g×3個 | 高たんぱ...1690円(563.4円/個)
[冷蔵]日本ルナ スキル バニラ 80g×3個 | 高たんぱ...1690円(563.4円/個) -
 [冷蔵]ダノンビオ 完熟ストロベリー ヨーグルト 75gx4...1790円(895円/個)
[冷蔵]ダノンビオ 完熟ストロベリー ヨーグルト 75gx4...1790円(895円/個) -
 [冷蔵]ダノンビオ 脂肪0 プレーン・加糖 ヨーグルト 75...3690円(615円/個)
[冷蔵]ダノンビオ 脂肪0 プレーン・加糖 ヨーグルト 75...3690円(615円/個) -
 [冷凍]江崎グリコ 牧場しぼり北海道産生クリーム仕立て生キャ...4990円(208円/個)
[冷凍]江崎グリコ 牧場しぼり北海道産生クリーム仕立て生キャ...4990円(208円/個) -
 フジサワ アーモンドフィッシュ (7g×40袋)×5個 | ...6090円(1218円/個)
フジサワ アーモンドフィッシュ (7g×40袋)×5個 | ...6090円(1218円/個) -
 [冷凍]ロッテ レディーボーデン パイント チョコレート 4...4790円(598.8円/個)
[冷凍]ロッテ レディーボーデン パイント チョコレート 4...4790円(598.8円/個) -
 [冷凍]あずきバ- 65ml×30個 | 井村屋独自の技術で...3390円(113円/個)
[冷凍]あずきバ- 65ml×30個 | 井村屋独自の技術で...3390円(113円/個) -
 [冷蔵]【栄養機能食品】日清ヨーク ピルクル 400 乳酸菌...2190円(730円/個)
[冷蔵]【栄養機能食品】日清ヨーク ピルクル 400 乳酸菌...2190円(730円/個) -
 フォワード ラカント業務用液状甘味料 1L | お砂糖の代わ...2590円
フォワード ラカント業務用液状甘味料 1L | お砂糖の代わ...2590円 -
 いなば食品 チキンとタイカレー イエロー 125g×12個 ...3490円(290.9円/個)
いなば食品 チキンとタイカレー イエロー 125g×12個 ...3490円(290.9円/個) -
 ダノンジャパン アルプロ オーツミルク 3種計9本セット(オ...2290円(254.5円/本)
ダノンジャパン アルプロ オーツミルク 3種計9本セット(オ...2290円(254.5円/本)
















![[3袋セット] 自然に優しい多用途洗浄剤「きれいッ粉(1kg)」※日本製](https://www.3ple.jp/images/168x168/publish/pay4ship/800000465457/image/1_20210526155319719.jpg)


![[2袋セット] 自然に優しい多用途洗浄剤「きれいッ粉(1kg)」※日本製](https://www.3ple.jp/images/168x168/publish/pay4ship/800000336996/image/1_20210526155141236.jpg)







































